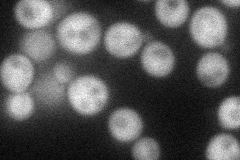
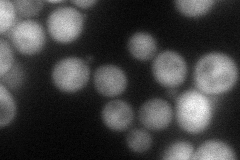

View description
Inositol 1,3,4,5,6-pentakisphosphate 2-kinase, nuclear protein required for synthesis of 1,2,3,4,5,6-hexakisphosphate (phytate), which is integral to cell function; has 2 motifs conserved in other fungi; ipk1 gle1 double mutant is inviable
Localization:
Intensity:
Fold change:
Significance:
-
C’ GFP library in SD

below threshold16.48 -
N' NOP1pr-GFP in SD
cytosol55.2582 -
N' TEF2pr-mCherry in SD
cytosol61.1679 -
N' NATIVEpr-GFP in SD

below threshold21.2426 -
N' TEF2pr-VC and Cyto-VN in SD

cytosol35.1106 -
C’ GFP library in SD+DTT

cytosol16.731.01No -
C’ GFP library in SD+H2O2

cytosol14.910.9No -
C’ GFP library in Starvation Media

cytosol20.351.23No -
C’ GFP library on the background of Pup2-DaMP

below threshold -
C’ GFP library on the background of CCT mutant

below threshold16.12070.977871No
